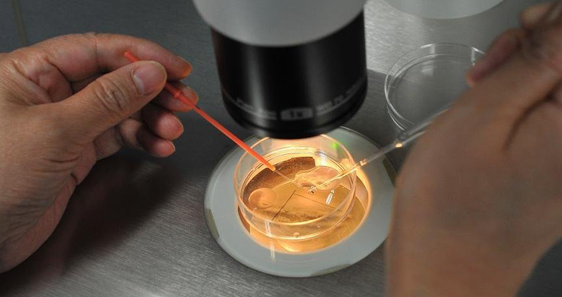

供精三代试管婴儿的技术实力
供精三代试管婴儿的技术实力南昌第一人民医院拥有先进的生殖医学技术和经验丰富的医师团队,能够为患者提供全方位、个性化的供精三代试管婴儿服务。医院引进国内外最先进的辅助生殖设备和技术,包括胚胎冷冻、胚胎活检等,确保了技术的领先性和安全性。
成功率及费用南昌第一人民医院供精三代试管婴儿的成功率在60%-75%之间,具体取决于患者的身体状况、年龄等因素。由于每位患者的情况不同,最终的成功率会根据详细检查和评估结果确定。
费用方面,南昌第一人民医院供精三代试管婴儿的总费用大约在95,876元左右,具体费用包含以下项目:
费用流程及试管移植过程1. 初始检查和咨询(约2,000 元):包括身体检查、生殖系统检查、遗传咨询等。
2. 激发方案和卵子取卵(约30,000元):根据患者的身体状况,选择合适的药物方案进行促排卵,然后在超声引导下提取成熟的卵子。
3. 精液处理和受精(约10,000元):将供精者的精液经过处理后与卵子进行体外受精,形成胚胎。
4. 胚胎培养和移植(约25,000元):观察并筛选优质胚胎,并在一定时间后将健康的胚胎移植到女性子宫内。
5. 孕期监测和产检:移植后需要定期进行b超检查、血常规等监测,确保妊娠顺利进展。
南昌第一人民医院优势总结南昌第一人民医院作为南昌市的一家知名大型医院,拥有雄厚的医疗实力和丰富的临床经验。医院在生殖医学方面特别注重技术创新和人才培养,拥有一支高素质的医护团队,他们始终致力于为患者提供安全、有效、个性化的辅助生殖服务。
结语选择合适的医院是供精三代试管婴儿成功的关键因素之一。根据以上介绍,您可以对南昌第一人民医院有更深入的了解。如果您有任何疑问或需要进一步咨询,请联系医院相关部门获取更多信息和专业的医疗建议。


还没有内容